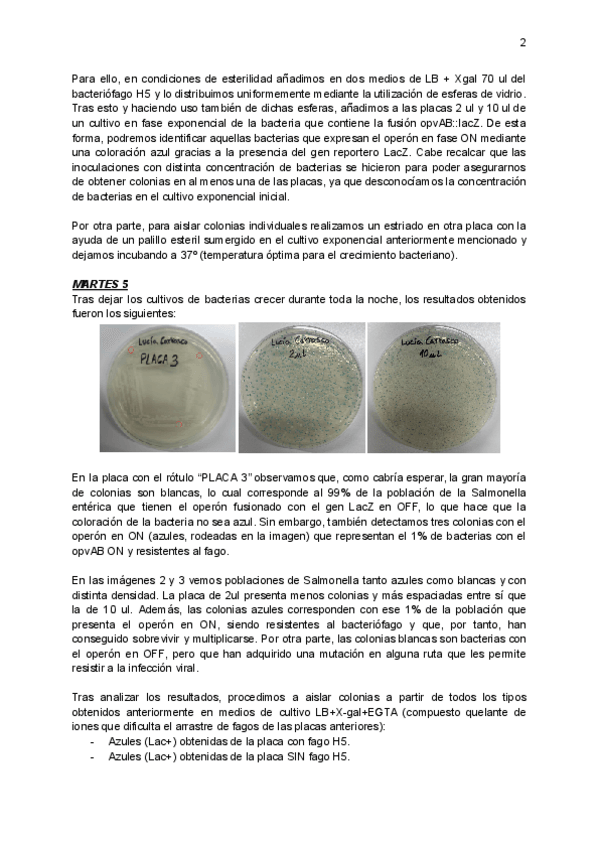

Epigenética
apuntes
-
Epigenética 25-26
He publicado nuevos apuntes de 4º Epigenética: Epigenética 25-26
apuntes
-
apuntes 25/26
He publicado nuevos apuntes de 1º Epigenética: apuntes 25/26
examenes
-
TESTS estudio/repaso
He publicado nuevos examenes de 4º Epigenética: TESTS estudio/repaso
He publicado nuevos ejercicios de 4º Epigenética: Preguntas-Socrative-Epigenetica.pdf
He publicado nuevos practicas de 4º Epigenética: Informe-Practicas-Epigenetica.pdf
apuntes
-
APUNTES EPIGENÉTICA 24/25 (NOTA 10)
He publicado nuevos apuntes de 4º Epigenética: APUNTES EPIGENÉTICA 24/25 (NOTA 10)
He publicado nuevos apuntes de 1º Epigenética: Influencia-Ambiental-apuntes.pdf
He publicado nuevos apuntes de 1º Epigenética: Epigenetica-y-cancer.pdf
He publicado nuevos test de 4º Epigenética: PREGUNTAS-SOCRATIVE-EPIGENETICA.pdf
He publicado nuevos practicas de 4º Epigenética: RESISTENCIA-EPIGENETICA-A-BACTERIOFAGOS.pdf
He publicado nuevos practicas de 4º Epigenética: INFORME-PRACTICAS-EPIGENETICA.pdf
apuntes
-
EPIGENÉTICA 23-24
He publicado nuevos apuntes de 4º Epigenética: EPIGENÉTICA 23-24
apuntes
-
EPIGENÉTICA 2022-2023
He publicado nuevos apuntes de 4º Epigenética: EPIGENÉTICA 2022-2023
He publicado nuevos apuntes de 4º Epigenética: Charla-Seminario-Externo.pdf
apuntes
-
Apuntes Epigenética 2022-23
He publicado nuevos apuntes de 4º Epigenética: Apuntes Epigenética 2022-23
apuntes
-
Series epigenética 21-22
Primero están los enunciados de los ejercicios y al final están las soluciones con los comentarios o correcciones del profesor en rojo
ejercicios
-
Series problemas 2020-21
He publicado nuevos ejercicios de 4º Epigenética: Series problemas 2020-21
apuntes
-
Apuntes 2021-2022
He publicado nuevos apuntes de 4º Epigenética: Apuntes 2021-2022
apuntes
-
Apuntes Epigenética 2021 2022
He publicado nuevos apuntes de 4º Epigenética: Apuntes Epigenética 2021 2022
apuntes
-
Apuntes
He publicado nuevos apuntes de 4º Epigenética: Apuntes
apuntes
-
Apuntes 2020/2021
He publicado nuevos apuntes de 4º Epigenética: Apuntes 2020/2021
apuntes
-
Epigenética
He publicado nuevos apuntes de 4º Epigenética: Epigenética
apuntes
-
Apuntes 2019/20
He publicado nuevos apuntes de 4º Epigenética: Apuntes 2019/20
He publicado nuevos apuntes de 4º Epigenética: RESUMEN EPIGENÉTICA.pdf
apuntes
-
Apuntes Epigenética
He publicado nuevos apuntes de 4º Epigenética: Apuntes Epigenética
apuntes
-
Epigenética 2015-2016
He publicado nuevos apuntes de 4º Epigenética: Epigenética 2015-2016
He publicado nuevos practicas de 4º Epigenética: Prácticas Epigenética 2015.pdf
trabajos
-
Series 2015-2016
He publicado nuevos trabajos de 4º Epigenética: Series 2015-2016